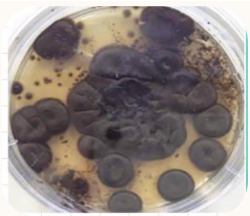
<ul><li><p><span><span>Slow growing</span></span></p></li><li><p><span><span>Silvery, velvety surface that turns black</span></span></p></li><li><p><span><span>Colonies slightly embed into media</span></span></p></li><li><p><span><span>Reverse in black</span></span></p></li></ul><p></p>
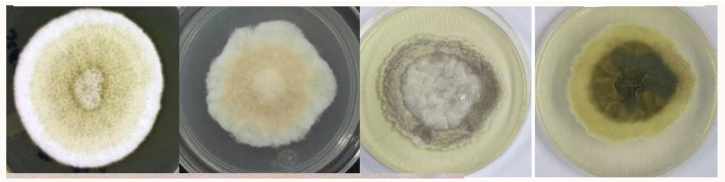
<ul><li><p><span><span>Formerly Pseudallescheria boydii</span></span></p></li><li><p><span><span>Mature in 7 days</span></span></p></li><li><p><span><span>White, spready cottony, aerial mycelium turns gray to dark brown as it ages</span></span></p></li><li><p><span><span>Reverse – white changing to black</span></span></p></li><li><p><span><u><span>Asexual state grows in presence of Cyclohexamide</span></u></span></p></li></ul><p></p>
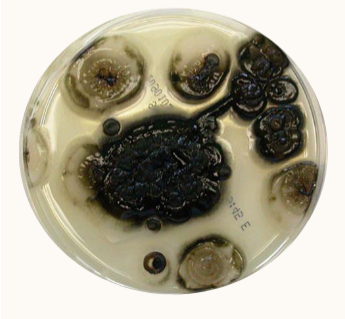
<ul><li><p><span><span>Starts as white, moist, creamy colonies</span></span></p></li><li><p><span><span>Develops brown/black shiny areas</span></span></p></li><li><p><span><span>Matures in 3-5 days</span></span></p></li><li><p><span><span>Reverse is black once mature</span></span></p></li></ul><p></p>
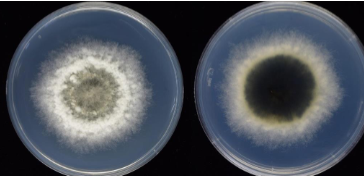
<p>(phaeohyphomycosis) biopularis sp </p>

1/29
Looks like no tags are added yet.
Name | Mastery | Learn | Test | Matching | Spaced |
|---|
No study sessions yet.
dematiaceous fungi
Brown to black pigment in the cell walls
Found more in tropical regions or where people go barefoot
Cause the following diseases:
Chromoblastomycosis
Mycetoma
Phaeohyphomycosis
Sporotrichosis
evidence for an organism being a pathogen instead of a contaminate
Isolation of organism from multiple cultures from the same location
Isolation of organism on more than one plate or tube of media
Isolation of organism from a normally sterile site
Ability of the organism to grow at 37 C
specimen types for subcutaneous fungi infections
Aspirates, biopsy material, scrapings, surgical tissue specimens
Protect from dehydration (except for skin scrapings)
Avoid the use of cotton swabs
Contains fatty acids
Cotton fibers look like hyphae
Difficult to get the material out of the cotton
(dematiaceous; subcutaneous) chromoblastomycosis
Acquired via traumatic inoculation
Papule develops
turns into a warty ‘cauliflower’ lesion
Hyphae near the surface
Muriform cells in the deeper tissues
Muriform cells, medlar bodies, sclerotic bodies, or “copper pennies”, is diagnostic for the disease

causative agents for chromoblastomycosis
Fonsecaeae pedrosoi
Cladophialophora carrionii
Phialophora verrucosa
Rhinocladiella aquaspersa
Exophiala jeanselmei
Exophiala spinifera


diagnosis of chromoblastomycosis
Skin scraping 10% KOH prep
Brown pigmented, planate-dividing rounded sclerotic bodies (aka copper pennis or muriform cells)
tissue biopsy

(chromoblastomycosis) phialophora verrucosa
Slow growing (7-12 days)
Suede-like texture
Colonies become embedded in the agar
Reverse is black

phialide vs annelide
Phialide: flared collarette
Annellide: tapered collarette with growth rings; need 100x to visualize


(chromoblastomycosis) fonsecaea pedrosi
A mould of many hats
4 sporulation patterns (1st pic)
a. Fonsecaea type ; b. Cladosporium type
c. Rhinocladiella type ; d. Philophora type
Fonsecaea type:
Denticle--short stalk-like structure from which conidia arise
Hard to see; Can be thin or swollen

colony morphology of fonsecaea pedrosi
Slow growing
Silvery, velvety surface that turns black
Colonies slightly embed into media
Reverse in black
(chromoblastomycosis) cladophialophora carrionii
Slow growing
Mature in 18 days
Velvety, dull dark surface
Reverse is black
Cladosporium type sporulation
somewhat poiny conidia

mycetoma
Chronic granulomatous infection
Primarily seen on the lower extremities
Swollen, purplish discoloration, tumor like deformities of the subcutaneous tissues
Multiple draining sinus tracts w/ pus and ‘sulfur’ granules
Painless Infection
Progresses to a bone infection and usually requires amputation
epidemiology of mycetoma
Found in tropical and hot temperate zones of the world
Not endemic in the USA
Those at risk:
Farmers / Field Workers
Sugarcane Workers
Fishermen

types of mycetoma (2)
Eumycotic– caused by dematiaceous fungi
Actinomycotic– caused by bacteria
Both are acquired by traumatic implantation
Everything except the etiological agent is the same
(mycetoma) exophiala jeanselmei complex colony morphology
Matures in 14 days
Grows slower or not at all at 37 C
Starts off as moist and skin like
Gradually develops velvety, short, mycelia
Reverse is black
colony can become elevated

(mycetoma) exophiala jeanselmei complex microscopic morphology
Slender annellides, sometimes branched
Conidia clustered at the end of the tapered annellide
Oval/elongated conidia

(mycetoma) scedosporium
Formerly Pseudallescheria boydii
Mature in 7 days
White, spready cottony, aerial mycelium turns gray to dark brown as it ages
Reverse – white changing to black
Asexual state grows in presence of Cyclohexamide
morphology of asexual stage of scedosporium
Septate hyphae
Conidiophores produce single conidia
Conidia appear cut off at base
Flattened end/truncate

sexual stage of scedosporium
Cleistothecia
Large sack
contain asci that contain ascospores when ruptured
development inhibited by cycloheximide

phaeohyphomycosis
Can be superficial, cutaneous, subcutaneous or invasive/systemic forms
May cause keratitis
Yeast-like cells and/or hyphae are seen in the tissues
No ‘unique’ structures seen
causative agents of phaeohyphomycosis (6)
rapidly growing moulds--mature in about 3-5 days
Alternaria
Aureobasidium
Bipolaris
Cladosporium
Curvularia
Hortaea
(phaeohyphomycosis) alternaria sp colony morphology
Wool surface with short aerial mycelia
Greyish-greenish-sometimes black
Light border
Reverse is black
Mature in 5 days

sporulation pattern of alternaria sp
racket-shaped conidia are the characteristics identification feature, regardless of the arrangement
AKA murifrom cells

(phaeohyphomycosis) aureobasidium pullulans colony morphology
Starts as white, moist, creamy colonies
Develops brown/black shiny areas
Matures in 3-5 days
Reverse is black once mature
hyphae of aureobasidium pullulans (2)
has 2 types:
Chains of darkly pigmented arthroconidia that break apart into arthrospores
Hyaline hyphae that produce oval hyaline conidia on denticles

(phaeohyphomycosis) biopularis sp
Gray/brown turning to black
Reverse is black
Matures in 5 days
genticulate/zig-zag conidiophore + dark conidia

germ tubes of biopularis sp (pic)


(phaeohyphomycosis) curvularia sp macro + microscopic morphology
Black wooly surface
Matures in 5 days
Reverse is black
Dark multi-celled conidia arise from pores on the Geniculate conidiophore
One of the central cells of the conidia grows faster than the others
That’s why it curves

(phaeohyphomycosis) hortaea werneckii
Formerly known as Wangiella werneckii
Slow grower—matures in 21 days
Moist, shiny, yeast-like at first
Starts brownish then becomes a dull olive black
Reverse is dark
2-celled, brown, yeast-like conidia w darkly pigmented septa

(phaeohyphomycosis) cladosporium sp colony morph + microscopic pic
Saprophytic contaminant, but still dematiaceous
Matures in 7 days
Greenish brown to black, becomes heaped, folded with a velvety texture
Very similar to Cladophilophora, except conidia are NOT pointy
